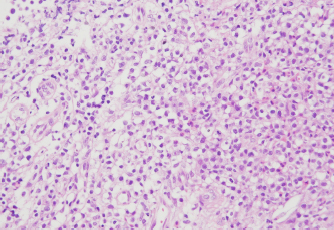

| Case Report | ||
Open Vet. J.. 2022; 12(3): 312-322 Open Veterinary Journal, (2022), Vol. 12(3): 312-322 Case Report Long-term survival of a feline with non-T/B large granular lymphocyte lymphoma treated with chemotherapy and activated lymphocyte therapyShimon Furusato1†, Yu Tamura2†, James K. Chambers3, Takahiro Ushigusa4 and Yu Tsuyama1,4*1Shinagawa WAF Animal Hospital, Tokyo, Japan 2Veterinary Teaching Hospital, Azabu University, Kanagawa, Japan 3Department of Veterinary Pathology, Graduate School of Agricultural and Life Science, Tokyo University, Tokyo, Japan 4Kannai Animal Clinic, Kanagawa, Japan †Both authors contributed equally to this work. *Corresponding Author: Yu Tsuyama. Shinagawa WAF Animal Hospital, 5-1-5 Osaki, Shinagawa-Ku, Tokyo, Japan. Email: yu.tsuyama [at] gmail.com Submitted: 07/01/2022 Accepted: 04/05/2022 Published: 15/05/2022 © 2022 Open Veterinary Journal
AbstractBackground: Feline large granular lymphocyte lymphoma (LGLL) is a grave prognosis. However, the effectiveness of concurrent treatment with chemotherapy and activated lymphocyte therapy for feline LGLL has not been evaluated. Case Description: A 7-year-old, castrated male, domestic cat presented with gastrointestinal symptoms and an abdominal mass. A Tru-Cut biopsy of the mass revealed LGLL. The cat responded well to chemotherapy regimens of cyclophosphamide, vincristine, prednisolone, and L-asparaginase. Furthermore, activated lymphocyte therapy was added as an adjuvant treatment. The cat survived 982 days from the first presentation and experienced few adverse events. Necropsy was performed and immunohistochemistry revealed that the neoplastic lymphocytes were CD3−/CD20− cells. The final diagnosis was non-T/B LGLL. Conclusion: Minimal physical burden and a good initial response to chemotherapy might have contributed to long-term survival in the present case. Moreover, activated lymphocyte therapy could be performed safely and may be a feasible treatment for feline non-T/B LGLL. Keywords: Activated lymphocyte therapy, Chemotherapy, Feline, Large granular lymphocyte, Lymphoma. IntroductionGastrointestinal lymphoma is a common type of cancer in cats (Sato et al., 2014; Economu et al., 2021). Among this type of lymphoma, the incidence of feline large granular lymphocyte lymphoma (LGLL) has been reported to be 6%–28% (Pohlman et al., 2009; Moore et al., 2012; Chino et al., 2013; Sato et al., 2014; Rau and Burgess, 2017). Feline LGLL is considered to have a more aggressive clinical course and is associated with poor prognosis [median survival time (MST)=29–60 days] (Krick et al., 2008; Sato et al., 2014; Finotello et al., 2018) compared with high-grade lymphomas (MST=86 days) (Sato et al., 2014). Although feline LGLL is a relatively common disease, optimal therapy remains unclear. Activated lymphocyte therapy is an adjuvant cancer treatment that enhances antitumor immunity because of the transfer of autologous-activated cytotoxic CD8+ T lymphocytes, which are stimulated in vitro with anti-CD3 antibodies and interleukin-2 (Itoh et al., 2003; Hoshino et al., 2008; Mie et al., 2016; Mitani et al., 2021). This therapy is generally administered in combination with chemotherapy in veterinary medicine (O’Connor and Wilson-Robles, 2014; Bujak et al., 2018). In human and canine cancer patients, concurrent treatment with activated lymphocyte therapy and chemotherapy decreased recurrence risk, improved the quality of life (QOL), or prolonged survival time without serious adverse events (Takayama et al., 2000; O’Connor et al., 2012, 2013; López-Díaz de Cerio et al., 2020; Mitani et al., 2021). Furthermore, activated lymphocyte therapy was reported to be safe and feasible for postoperative QOL maintenance in older feline cancer patients (Maeta et al., 2019). However, there are no reports on the administration of activated lymphocyte therapy for feline LGLL. Herein, we report a case of a feline with LGLL that underwent concurrent treatment with chemotherapy and activated lymphocyte therapy and had a long-term favorable survival. Case DetailsA 7-year-old, castrated male, domestic cat weighing 4.2 kg was presented with a 1-week history of continuous vomiting, diarrhea, and anorexia (day 1). Clinical examination revealed fever (40.0°C) and a palpable irregular abdominal mass. Hematological (Celltac Alpha; NIHON KOHDEN, Tokyo, Japan) and serum biochemistry (VetTest Chemistry Analyzer; IDEXX, ME) measurements revealed mild leukocytosis [26,500 cells/μl; reference interval (RI)=5500–19,500 cells/μl] and elevation of hepatic enzyme concentrations [alanine aminotransferase (ALT)=370 U/l; RI=12–130 U/l; aspartate aminotransferase (AST)=190 U/l; RI=0–48 U/l]. We conducted Diff-Quik-stained peripheral blood smear microscopy. We observed that segmented neutrophils were predominant in the white blood cells. Additionally, a few band neutrophils and normal morphological lymphocytes were diffused in the smear. We could not observe atypical lymphocytes, such as large or irregular shapes. Therefore, we concluded neutrophilia and no neoplastic cells infiltration in a peripheral blood smear. Feline immunodeficiency virus antibody and feline leukemia virus antigen tests yielded negative results. No abnormalities were observed in urine or fecal specimens. Thoracic radiographs were unremarkable; however, abdominal radiographs revealed an irregularly rounded, opaque, soft tissue mass (4 cm in diameter) in the mid-ventral abdomen. Abdominal ultrasonography (Apron EUB-7000HV; Hitachi Medical, Tokyo, Japan) revealed an irregularly rounded, heterogeneous, hypoechoic abdominal mass (4.25 cm in diameter) that had developed within a mesenteric lymph node. The width of the abdominal mass was measured at the widest diameter and followed up using ultrasonography throughout the treatment period (Fig. 1). A Tru-Cut biopsy was performed on the abdominal mass with the patient under sedation (day 2). The cytology was performed with Wright-Giemsa-stained smear preparations of the Tru-Cut biopsy samples at the hospital, revealing many atypical round cells with chromatin aggregation and irregular nuclear morphology. We clinically diagnosed the patient with lymphoma and began treatment before histopathological diagnosis because of the rapid deterioration of the patient’s general condition, which included weight loss and anorexia. On day 3, we began a combination chemotherapy regimen with cyclophosphamide (Endoxan; Shionogi; 50 mg/m2 PO q48h), vincristine (Oncovin; Nippon Kayaku; 0.025 mg/kg IV q1w), prednisolone (Predonine; Shionogi; 2 mg/kg PO q24h) (COP-based chemotherapy), and L-asparaginase (Leunase; Kyowa Kirin; 400 U/kg SC), which is a modified version of the regimen used in a previous study (Simon et al., 2008). The dose of prednisolone was tapered 1 week after beginning chemotherapy.
Fig. 1. The diameter of the abdominal mass over time. The widest point of the abdominal mass was measured using ultrasonography during treatment and until death. Each event is indicated by black arrows. LGLL, large granular lymphocyte lymphoma. Cytological and histopathological analyses of the Tru-Cut biopsy sample were conducted by a veterinary pathologist (J.K.C.). Cytology revealed numerous round cells with medium-sized nuclei. These cells exhibited moderate to high nucleus/cytoplasm ratios, anisocytosis, and anisokaryosis. The nuclei showed irregular, round, and fine-to-stippled chromatin. The cytoplasm often contained basophilic granules and/or vacuoles. Lymphocytes, neutrophils, and eosinophils were admixed. Histopathologically, severe infiltration by neoplastic lymphocytes with medium-sized, irregularly shaped nuclei and clear cytoplasm was observed; a small number of eosinophils were found admixed with these cells (Fig. 2). Based on these findings, the abdominal mass was diagnosed as LGLL, which had developed within the mesenteric lymph nodes. We informed the owner that feline LGLL has a grave prognosis, even with chemotherapy. Although it had never been administered for feline LGLL, we explained to the owner that activated lymphocyte therapy is expected to have antitumor efficacy and is considered to be safe based on the reports of this treatment in other species (Takayama et al., 2000; O’Connor et al., 2012, 2013; Mie et al., 2016). After discussion with the owner, activated lymphocyte therapy was administered as an adjuvant therapy in combination with COP-based chemotherapy instead of intensified chemotherapy to avoid excessive patient burden. On day 53, we began activated lymphocyte therapy using the CD3-activated T lymphocyte culture kit (J-ARM Co., Ltd.) as per the manufacturer’s protocol. Briefly, peripheral blood mononuclear cells (PBMCs) were isolated using density-gradient centrifugation of 10 ml of venous blood collected from the patient. PBMCs were cultured with a lymphocyte growth medium containing human recombinant IL-2 and 10% autologous plasma in an anti-CD3 antibody-coated flask at 37°C in 5% CO2 for 2 weeks. The cultured cells collected using centrifugation were then suspended in 50 ml of saline and transfused into the patient intravenously over 30 minutes. Simultaneously, we assessed the number of viable cells, the presence of atypical lymphocytes, and contamination in cultured cell suspension using trypan blue staining. We conducted a total of 28 sessions of activated lymphocyte therapy with a 3–4-week interval until the first 11 sessions were completed. The mean viable cell numbers for each transfusion were 1.45 × 108 cells. There was no contamination or atypical lymphocyte proliferation in any procedures. During the treatments, the patient showed no abnormal signs. Details of the treatment regimens are presented in Table 1. From the initial chemotherapy, the patient’s condition improved, and the abdominal mass was reduced to less than 10 mm at the widest diameter. On day 304, we withdrew the COP-based chemotherapy at the owner’s request; however, activated lymphocyte therapy was continued with an interval of at least 2 weeks between doses with few side effects. Grade 1–2 AST level elevation and grade 1 creatinine level elevation/neutropenia, diagnosed based on the Veterinary Cooperative Oncology Group-Common Terminology Criteria for Adverse Events (LeBlanc et al., 2021), were observed temporarily during the treatments.
Fig. 2. Histopathology of the Tru-Cut biopsy sample from the abdominal mass. Hematoxylin and eosin staining (200× magnification). Severe infiltration by neoplastic lymphocytes with medium-sized, irregularly shaped nuclei and clear cytoplasm was observed. We observed enlargement of the abdominal mass on day 488 and concluded that there was LGLL progression. Fine-needle aspiration (FNA) of the mass was conducted on day 558, and the FNA samples were analyzed using polymerase chain reaction for antigen receptor rearrangements (PARR) (Mochizuki et al., 2011, 2012) and flow cytometry at a commercial laboratory (Canine-lab) using the antibodies listed in Table 2. The cell suspension of the culture medium and patient’s blood were also analyzed with flow cytometry. PARR did not detect monoclonal amplification of T cell receptor gamma or immunoglobulin H genes in the FNA samples. Flow cytometry revealed that the aspirate largely comprised non-T/B lymphocytes (96.60%) in the FNA samples and CD8+ T lymphocytes (70.38%) in the culture medium (Table 3). After LGLL progression, we readministered COP-based chemotherapy with L-asparaginase and continued activated lymphocyte therapy; however, the size of the abdominal mass increased and the patient failed to respond to the treatment. As a rescue protocol, we administered doxorubicin (Adriacin; Kyowa Kirin; 20 mg/m2 IV) and lomustine (CeeNU; Bristol-Myers Squibb; 40 mg/m2 PO) with the owner’s consent on days 684 and 745, respectively. Then, lomustine administration was continued with a 1-month interval between treatments. We discontinued cyclophosphamide treatment after day 684. Temporal grade 1–3 AST level elevation, grade 1 creatinine level elevation, and grade 1 alopecia were observed after the rescue protocol. The patient’s condition was stable and the abdominal mass rapidly decreased in size after administration of doxorubicin. However, the abdominal mass size increased subsequently, and we found circulating neoplastic cells in the patient’s peripheral blood on day 909. The cat presented with diarrhea, rapidly decreasing appetite, and anorexia beginning on day 972 and died at home on day 982. Table 1. The treatment time course.
Table 2. Antibodies used in flow cytometry.
Table 3. Percentage of lymphocyte phenotypes.
A postmortem examination was performed. Cytology was performed by staining with Wright-Giemsa. The visceral organs were fixed in 10% neutral-buffered formalin, embedded in paraffin, sectioned at 4-μm thickness, and stained with hematoxylin and eosin for histopathology. Immunohistochemistry was performed using primary antibodies as previously described (Hirabayashi et al., 2019). Stamp cytology of the liver, spleen (Fig. 3), axillary lymph nodes, and bone marrow revealed large numbers of round cells with large cytoplasmic granules. Histopathology revealed infiltration of neoplastic lymphocytes in the liver, spleen, heart, ileum (Fig. 4a), and pancreaticoduodenal and axillary lymph nodes. Neoplastic lymphocytes were medium-sized with moderate anisocytosis and anisokaryosis. The nuclear membranes were often irregular, and the nuclei had a distinct nucleolus and fine-to-stippled chromatin. Mitotic count (MC) was 11 per 2.37 mm2 [equal to 10 high power fields (HPF) at 400× magnification] in the tumor regions of the ileum based on a previously established guideline (Meuten et al., 2021). Immunohistochemistry revealed abundant granzyme B-positive, cytoplasmic granules in the neoplastic lymphocytes, which were also negative for CD3 and CD20 (Fig. 4b–d). Ethical approvalAll procedures were performed for an owned cat. Informed consent was obtained from the owner and they approved the management of the case and procedures. Therefore, additional ethical approval was not required. DiscussionWe report a case of a feline with LGLL treated with combination treatment with chemotherapy and activated lymphocyte therapy that survived for 982 days after initial presentation. Flow cytometry, PARR, and immunohistochemistry revealed that the abdominal mass in the present case was LGLL of non-T/B lymphocyte origin, which type of lineage existence is consistent with the findings of previous studies (Roccabianca et al., 2006; Pohlman et al., 2009). In a previous study, the mean survival time of patients with non-T/B LGLL was 17.5 days (Roccabianca et al., 2006). However, several feline LGLL patients survived for over 180 days, suggesting the existence of an LGLL subtype with a good prognosis (Krick et al., 2008; Sapierzyński et al., 2015; Rau and Burgess, 2017; Finotello et al., 2018). The possible reasons for the long-term favorable survival in the present case are presented below. first, there was minimal impact on organ systems. Retrospective studies reported that poor prognostic factors for feline LGLL were bicavitary involvement and hypoalbuminemia or the presence of symptoms and increased serum levels of lactate dehydrogenase (Krick et al., 2008; Finotello et al., 2018). During most of the treatment period, the cat in the present case was asymptomatic and had temporal low-grade adverse events without bicavitary involvement, hypoalbuminemia, or lactate dehydrogenase level elevation; the low physical burden may have contributed to the long-term survival. Second, there was a good initial response to chemotherapy. A retrospective study demonstrated that 7.3% of feline LGLL patients survived over 180 days; 75.0% of these patients were treated with cyclophosphamide, doxorubicin, vincristine, and prednisolone (CHOP)-based chemotherapy; and a lack of response to chemotherapy was a poor prognostic factor (Finotello et al., 2018). These results suggested the existence of a feline LGLL subtype that could respond well to chemotherapy and result in long-term survival. Moreover, in feline lymphoma, a good initial response to COP-based chemotherapy is correlated with prolonged overall survival time (Waite et al., 2013). In our case, tumor regression and improvement of clinical signs were observed soon after beginning COP-based chemotherapy; therefore, a good initial response might have been associated with this patient’s long-term survival. Third, there was relatively low mitotic activity [MC=11 per 2.37 mm2 (10 HPF)] in the ileum at postmortem examination. This MC can be converted to 1.1 per 1 HPF. Furthermore, the present MC could be categorized as low grade (0–5 per 1 HPF) according to the World Health Organization system of classification of canine lymphomas (Valli et al., 2011). A retrospective study revealed that higher MC (> 20 per 1 HPF) indicated poor survival probability in canine lymphoma (Valli et al., 2013). Furthermore, a case report of a feline with T LGLL surviving for 1 month from the onset had higher MC (4–5 per 1 HPF) (Tsuboi et al., 2010) than the present case. Therefore, relatively low mitotic activity might have resulted in a good prognosis in this case. However, we should note the several limitations below. First, the statistical association between MC and prognosis in feline LGLL remains unclear in veterinary medicine. Second, autopsy specimens (posttreatment) were used in this MC evaluation, hence, the MC of pretreatment conditions remains unknown. Third, MC evaluation methods often differed in magnifications and number of fields among studies, leading to a lack of comparability.
Fig. 3. Infiltration of neoplastic lymphocytes in the spleen. Cytology staining with Wright-Giemsa (1000× magnification). Numerous neoplastic round cells with medium-sized nuclei in the spleen. The cytoplasm contained numerous amphophilic granules (1–2 µm in diameter).
Fig. 4. Infiltration of neoplast3c lymphocytes in the ileum. (a) Hematoxylin and eosin staining (200× magnification). (b) Granzyme B-positive cytoplasmic granules in the neoplastic lymphocytes. Immunohistochemistry (IHC) for granzyme B (200× magnification). Neoplastic lymphocytes were negative for (c) CD3 and (d) CD20. IHC for CD3 and CD20 (× 40 magnification). Activated lymphocyte therapy was administered multiple times in combination with chemotherapy without serious adverse events over a long period in the present case. Based on flow cytometry results that CD8+ T lymphocytes were mainly composed in the culture medium, we assumed an enhancement effect of antitumor immunity, referred to the findings of previous studies (Itoh et al., 2003; Hoshino et al., 2008; Mie et al., 2016; Mitani et al., 2021). Several studies indicated that chemotherapy could synergistically enhance the effect of the activated lymphocyte for the following reasons. First, the chance of tumor-antigen sensitization to immune cells increases by chemotherapy cytotoxicity (Mitchell et al., 2012). Second, a low-dose metronomic cyclophosphamide protocol induces selective reduction of circulating regulatory T lymphocyte levels, which contributes to immune tolerance (Ghiringhelli et al., 2007; Burton et al., 2011). Based on the findings of these studies, concurrent treatment with chemotherapy and activated lymphocyte therapy could be preferred to activated lymphocyte therapy alone; however further controlled studies are required to clarify the efficacy of activated lymphocyte therapy for feline LGLL. Moreover, the potential toxicity and safety issues of the activated lymphocyte therapy make the use of this therapy controversial, although some reports have described that this therapy is safe in cats and other species (Takayama et al., 2000; Hoshino et al., 2008; O’Connor et al., 2012; Maeta et al., 2019; López-Díaz de Cerio et al., 2020; Gareau et al., 2021; Mitani et al., 2021). In a human randomized trial, compared with surgical resection alone, activated lymphocyte therapy after surgical resection of hepatocellular carcinoma decreased the frequency of recurrence, prolonged the time to first recurrence, improved the recurrence-free survival, and improved the disease-specific survival (Takayama et al., 2000). Furthermore, in a controlled study of canines, compared with chemotherapy alone, activated lymphocyte therapy after chemotherapy for lymphoma prolonged tumor-free and overall survival time (O’Connor et al., 2012). In these studies, the patients had few adverse side effects. Additionally, the safety of activated lymphocyte therapy was described in some veterinary articles: a retrospective study described that no adverse events were observed in 10 dogs with lymphoma that received multiple doses of activated lymphocyte therapy after chemotherapy (Gareau et al., 2021). Furthermore, two cats treated with activated lymphocyte therapy after surgical resection of carcinomas over several months maintained their QOL and showed no adverse events (Maeta et al., 2019). Long-term survival was observed in a feline patient with non-T/B LGLL treated concurrently with chemotherapy and activated lymphocyte therapy. Using a treatment regimen for feline non-T/B LGLL with a minimal physical burden and having a good initial response to treatment may prolong survival. Activated lymphocyte therapy may be a feasible adjuvant treatment for feline non-T/B LGLL. AcknowledgmentsThe authors thank all the staff at Shinagawa WAF Animal Hospital for facilitating a smooth operation during this work. The first author would also like to express the deepest appreciation to Akane Kantake for her dedicated support during this work. They would like to thank Editage (www.editage.com) for the English language editing. Conflict of interestThe authors declare that there is no conflict of interest. Authors’ contributionsShimon Furusato and Yu Tamura contributed to the analysis and interpretation of the data and writing of the first draft. James K. Chambers performed the pathological diagnosis and wrote the section regarding the pathological analysis in the manuscript. Takahiro Ushigusa and Yu Tsuyama contributed to the clinical case resolution, data collection, and critical revision of the manuscript. All of them reviewed and revised the final draft. ReferencesBujak, J.K., Pingwara, R., Nelson, M.H. and Majchrzak, K. 2018. Adoptive cell transfer: new perspective treatment in veterinary oncology. Acta. Vet. Scand. 60, 60. Burton, J.H., Mitchell, L., Thamm, D.H., Dow, S.W. and Biller, B.J. 2011. Low-dose cyclophosphamide selectively decreases regulatory T cells and inhibits angiogenesis in dogs with soft tissue sarcoma. J. Vet. Intern. Med. 25, 920–926. Chino, J., Fujino, Y., Kobayashi, T., Kariya, K., Goto-Koshino, Y., Ohono, K., Nakayama, H. and Tsujimoto, H. 2013. Cytomorphological and immunological classification of feline lymphomas: Clinicopathological features of 76 cases. J. Vet. Med. Sci. 75, 701–707. Economu, L., Stell, A., O’Neill, D.G., Schofield, I., Stevens, K. and Brodbelt, D. 2021. Incidence and risk factors for feline lymphoma in UK primary-care practice. J. Small Anim. Pract. 62, 97–106. Finotello, R., Vasconi, M.E., Sabattini, S., Agnoli, C., Giacoboni, C., Annoni, M., Dentini, A., Bettini, G., Guazzi, P., Stefanello, D., Bottero, E., Mesto, P., Marinelli, R., Feo, C.D. and Marconato, L. 2018. Feline large granular lymphocyte lymphoma: An Italian Society of Veterinary Oncology (SIONCOV) retrospective study. Vet. Com. Oncol. 16, 159–166. Gareau, A., Ripoll, A.Z. and Suter, S.E. 2021. A retrospective analysis: autologous peripheral blood hematopoietic stem cell transplant combined with adoptive T-cell therapy for the treatment of high-grade B-cell lymphoma in ten dogs. Front. Vet. Sci. 8, 787373. Ghiringhelli, F., Menard, C., Puig, P.E., Ladoire, S., Roux, S., Martin, F., Solary, E., Cesne, A.L., Zitvogel, L. and Chauffert, B. 2007. Metronomic cyclophosphamide regimen selectively depletes CD4+CD25+ regulatory T cells and restores T and NK effector functions in end stage cancer patients. Cancer Immunol. Immunother. 56, 641–648. Hirabayashi, M., Chambers, J.K., Sugawara, M., Ohmi, A., Tsujimoto, H., Nakayama, H. and Uchida, K. 2019. Blastic natural killer cell lymphoma/leukemia in a cat. JFMS Open Rep. 5, 2055116919863080. Hoshino, Y., Takagi, S., Osaki, T., Okumura, M. and Fujinaga, T. 2008. Phenotypic analysis and effects of sequential administration of activated canine lymphocytes on healthy beagles. J. Vet. Med. Sci. 70, 581–588. Itoh, H., Kakuta, T., Kudo, T., Sakonju, I., Hohdatsu, T., Ebina, T. and Takase, K. 2003. Bulk cultures of canine peripheral blood lymphocytes with solid phase anti-CD3 antibody and recombinant interleukin-2 for use in immunotherapy. J. Vet. Med. Sci. 65, 329–333. Krick, E.L., Little, L., Patel, R., Shofer, F.S., Sorenmo, K., Clifford, C.A. and Baez, J.L. 2008. Description of clinical and pathological findings, treatment and outcome of feline large granular lymphocyte lymphoma (1996–2004). Vet. Com. Oncol. 6, 102–110. LeBlanc, A.K., Atherton, M., Bentley, R.T., Boudreau, C.E., Burton, J.H., Curran, K.M., Dow, S., Giuffrida, M.A., Kellihan, H.B., Mason, N.J., Oblak, M., Selmic, L.E., Selting, K.A., Singh, A., Tjostheim, S., Vail, D.M., Weishaar, K.M., Berger, E.P., Rossmeisl, J.H. and Mazcko, C. 2021. Veterinary Cooperative Oncology Group—Common Terminology Criteria for Adverse Events (VCOG-CTCAE v2) following investigational therapy in dogs and cats. Vet. Comp. Oncol. 19, 311–352. López-Díaz de Cerio A, García-Muñoz, R., Pena, E., Panizo, Á., Feliu, J., Giraldo, P., Rodríguez-Calvillo, M., Martínez-Calle, N., Grande, C., Olave, M.T., Andrade-Campos, M., Bandrés, E., Núñez-Córdoba, J.M., Inogés, S. and Panizo, C. 2020. Maintenance therapy with ex vivo expanded lymphokine-activated killer cells and rituximab in patients with follicular lymphoma is safe and may delay disease progression. Br. J. Haematol. 189, 1064–1073. Maeta, N., Tamura, K., Takemitsu, H. and Miyabe, M. 2019. Lymphokine-activated killer cell transplantation after anti-cancer treatment in two aged cats. Open Vet. J. 9, 147–150. Meuten, D.J., Bertram, C.A., Moore, F.M, Aubreville, M., Donovan, T.A., Klopfleisch, R. and Luong, R. 2021. Mitotic Count Guideline, version 1.0. Veterinary Cancer Guidelines and Protocols. http://vetcancerprotocols.org (Accessed 5 January 2022). Mie, K., Shimada, T., Akiyoshi, H., Hayashi, A. and Ohashi, F. 2016. Change in peripheral blood lymphocyte count in dogs following adoptive immunotherapy using lymphokine-activated T killer cells combined with palliative tumor resection. Vet. Immunol. Immunopathol. 177, 58–63. Mitani, K., Ito, Y., Takene, Y., Hatoya, S., Sugiura, K. and Inaba, T. 2021. Quality of life-improving effect of autologous ex vivo expanded cytotoxic and opioid-producing lymphocytes for dogs with cancers. Vet. Immunol. Immunopathol. 238, 110292. Mitchell, L., Dow, S.W., Slansky, J.E. and Biller, B.J. 2012. Induction of remission results in spontaneous enhancement of anti-tumor cytotoxic T-lymphocyte activity in dogs with B cell lymphoma. Vet. Immunol. Immunopathol. 145, 597–603. Mochizuki, H., Nakamura, K., Sato, H., Goto-Koshino, Y., Sato, M., Takahashi, M., Fujino, Y., Ohno, K., Uchida, K., Nakayama, H. and Tsujimoto, H. 2011. Multiplex PCR and Genescan analysis to detect immunoglobulin heavy chain gene rearrangement in feline B-cell neoplasms. Vet. Immunol. Immunopathol. 143, 38–45. Mochizuki, H., Nakamura, K., Sato, H., Goto-Koshino, Y., Sato, M., Takahashi, M., Fukushima, K., Nakashima, K., Fujino, Y., Ohno, K., Uchida, K., Nakayama, H. and Tsujimoto, H. 2012. GeneScan analysis to detect clonality of T-cell receptor γ gene rearrangement in feline lymphoid neoplasms. Vet. Immunol. Immunopathol. 145, 402–409. Moore, P.F., Rodriguez-Bertos, A. and Kass, P.H. 2012. Feline gastrointestinal lymphoma: mucosal architecture, immunophenotype, and molecular clonality. Vet. Pathol. 49, 658–668. O’Connor, C.M., Ang, S., Maiti, S., McNamara, G., Sheppard, S., Miller, T., Huls, H., Champlin, R.E., Wilson, H. and Cooper, L.J.N. 2013. Immune reconstitution with activated T cells in companion canines with lymphoma [Abstract]. Blood. 122, 5153. O’Connor, C.M., Sheppard, S., Hartline, C.A., Huls, H., Johnson, M., Palla, S.L., Maiti, S., Ma, W., Davis, R.E., Craig, S., Lee, D.A., Champlin, R., Wilson, H. and Cooper, L.J.N. 2012. Adoptive T-cell therapy improves treatment of canine non–Hodgkin lymphoma post chemotherapy. Sci. Rep. 2, 249. O’Connor, C.M. and Wilson-Robles, H. 2014. Developing T cell cancer immunotherapy in the dog with lymphoma. ILAR J. 55, 169–181. Pohlman, L.M., Higginbotham, M.L., Welles, E.G. and Johnson, C.M. 2009. Immunophenotypic and histologic classification of 50 cases of feline gastrointestinal lymphoma. Vet. Pathol. 46, 259–268. Rau, S.E. and Burgess, K.E. 2017. A retrospective evaluation of lomustine (CeeNU) in 32 treatment naïve cats with intermediate to large cell gastrointestinal lymphoma (2006–2013). Vet. Comp. Oncol. 15, 1019–1028. Roccabianca, P., Vernau, W., Caniatti, M. and Moore, P. F. 2006. Feline large granular lymphocyte (LGL) lymphoma with secondary leukemia: primary intestinal origin with predominance of a CD3/CD8(alpha)(alpha) phenotype. Vet. Pathol. 43, 15–28. Sapierzyński, R., Jankowska, U., Jagielski, D. and Kliczkowska-Klarowicz, K. 2015. Large granular lymphoma in six cats. Pol. J. Vet. Sci. 18, 163–169. Sato, H., Fujino, Y., Chino, J., Takahashi, M., Fukushima, K., Goto-Koshino, Y., Uchida, K., Ohno, K. and Tsujimoto, H. 2014. Prognostic analyses on anatomical and morphological classification of feline lymphoma. J. Vet. Med. Sci. 76, 807–811. Simon, D., Eberle, N., Laacke-Singer, L. and Nolte, I. 2008. Combination chemotherapy in feline lymphoma: Treatment outcome, tolerability, and duration in 23 cats. J. Vet. Intern. Med. 22, 394–400. Takayama, T., Sekine, T., Makuuchi, M., Yamasaki, S., Kosuge, T., Yamamoto, J., Shimada, K., Sakamoto, M., Hirohashi, S., Ohashi, Y. and Kakizoe, T. 2000. Adoptive immunotherapy to lower postsurgical recurrence rates of hepatocellular carcinoma: a randomized trial. Lancet. 356, 802–807. Tsuboi, M., Uchida, K., Park, E.S., Kotera, Y., Seki, T., Takahashi, M. and Nakayama, H. 2010. Systemic T cell large granular lymphocyte lymphoma with multifocal white matter degeneration in the brain of a Japanese domestic cat. J. Vet. Med. Sci. 72, 795–799. Valli, V. E., San Myint, M., Barthel, A., Bienzle, D., Caswell, J., Colbatzky, F., Durham, A., Ehrhart, E.J., Johnson, Y., Jones, C., Kiupel, M., Labelle, P., Lester, S., Miller, M., Moore, P., Moroff, S., Roccabianca, P., Ramos-Vara, J., Ross, A., Scase, T., Tvedten, H. and Vernau, W. 2011. Classification of canine malignant lymphomas according to the World Health Organization criteria. Vet. Pathol. 48, 198–211. Valli, V.E., Kass, P.H., San Myint, M. and Scott, F. 2013. Canine lymphomas: association of classification type, disease stage, tumor subtype, mitotic rate, and treatment with survival. Vet. Pathol. 50, 738–748. Waite, A.H.K., Jackson, K., Gregor, T.P. and Krick, E.L. 2013. Lymphoma in cats treated with a weekly cyclophosphamide-, vincristine-, and prednisone-based protocol: 114 cases (1998–2008). J. Am. Vet. Med. Assoc. 242, 1104–1109. | ||
| How to Cite this Article |
| Pubmed Style Furusato S, Tamura Y, Chambers JK, Ushigusa T, Tsuyama Y. Long-term survival of a feline with non-T/B large granular lymphocyte lymphoma treated with chemotherapy and activated lymphocyte therapy. Open Vet. J.. 2022; 12(3): 312-322. doi:10.5455/OVJ.2022.v12.i3.2 Web Style Furusato S, Tamura Y, Chambers JK, Ushigusa T, Tsuyama Y. Long-term survival of a feline with non-T/B large granular lymphocyte lymphoma treated with chemotherapy and activated lymphocyte therapy. https://www.openveterinaryjournal.com/?mno=140892 [Access: January 25, 2026]. doi:10.5455/OVJ.2022.v12.i3.2 AMA (American Medical Association) Style Furusato S, Tamura Y, Chambers JK, Ushigusa T, Tsuyama Y. Long-term survival of a feline with non-T/B large granular lymphocyte lymphoma treated with chemotherapy and activated lymphocyte therapy. Open Vet. J.. 2022; 12(3): 312-322. doi:10.5455/OVJ.2022.v12.i3.2 Vancouver/ICMJE Style Furusato S, Tamura Y, Chambers JK, Ushigusa T, Tsuyama Y. Long-term survival of a feline with non-T/B large granular lymphocyte lymphoma treated with chemotherapy and activated lymphocyte therapy. Open Vet. J.. (2022), [cited January 25, 2026]; 12(3): 312-322. doi:10.5455/OVJ.2022.v12.i3.2 Harvard Style Furusato, S., Tamura, . Y., Chambers, . J. K., Ushigusa, . T. & Tsuyama, . Y. (2022) Long-term survival of a feline with non-T/B large granular lymphocyte lymphoma treated with chemotherapy and activated lymphocyte therapy. Open Vet. J., 12 (3), 312-322. doi:10.5455/OVJ.2022.v12.i3.2 Turabian Style Furusato, Shimon, Yu Tamura, James K Chambers, Takahiro Ushigusa, and Yu Tsuyama. 2022. Long-term survival of a feline with non-T/B large granular lymphocyte lymphoma treated with chemotherapy and activated lymphocyte therapy. Open Veterinary Journal, 12 (3), 312-322. doi:10.5455/OVJ.2022.v12.i3.2 Chicago Style Furusato, Shimon, Yu Tamura, James K Chambers, Takahiro Ushigusa, and Yu Tsuyama. "Long-term survival of a feline with non-T/B large granular lymphocyte lymphoma treated with chemotherapy and activated lymphocyte therapy." Open Veterinary Journal 12 (2022), 312-322. doi:10.5455/OVJ.2022.v12.i3.2 MLA (The Modern Language Association) Style Furusato, Shimon, Yu Tamura, James K Chambers, Takahiro Ushigusa, and Yu Tsuyama. "Long-term survival of a feline with non-T/B large granular lymphocyte lymphoma treated with chemotherapy and activated lymphocyte therapy." Open Veterinary Journal 12.3 (2022), 312-322. Print. doi:10.5455/OVJ.2022.v12.i3.2 APA (American Psychological Association) Style Furusato, S., Tamura, . Y., Chambers, . J. K., Ushigusa, . T. & Tsuyama, . Y. (2022) Long-term survival of a feline with non-T/B large granular lymphocyte lymphoma treated with chemotherapy and activated lymphocyte therapy. Open Veterinary Journal, 12 (3), 312-322. doi:10.5455/OVJ.2022.v12.i3.2 |